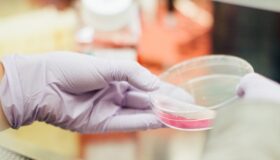

Етикет: рак
Проучване установява, че бамбукът крие високо съдържание на протеини, подобно на кравето мляко
Констатациите могат да помогнат за предотвратяване на заболявания като затлъстяване, диабет и рак.
Приблизително 68 процента от населението на планетата има непоносимост към лактоза. От...
Създала ли е Русия ваксина срещу рак?
В изненадващо съобщение руският президент, Владимир Путин обявява обещаващ пробив в изследванията на рака по време на технологичен форум в Москва. Путин казва, че руски...
Открита е връзка между консумацията на ултрапреработените храни и рака на устата и гърлото
Според ново проучване, ръководено от изследователи от Университета в Бристол и Международната агенция за изследване на рака (IARC), консумацията на повече ултрапреработени храни (UPF)...
Сапун за лечение на меланом: 14-годишен изобретява сапун за борба с рака
Сапунът за лечение на меланом (MTS) е създаден с помощта на химикали за борба с рака, главно имидазохинолин, интегриран с преносител на частици на...
Учени откриват малка верига от РНК, която е ключова за борбата с рака на...
Екип от изследователи от Университета на Масачузетс, Амхърст показва как една малка верига от микроРНК, известна като let-7, управлява способността на Т-клетките да разпознават...
Изключителен имунитет: Прилепите крият жизненоважни улики за превенция на рака
Ново проучване показва, че прилепите са еволюирали, за да избегнат рака и знанието как точно го правят може да помогне на хората да се...
Новооткрити свръх Т-клетки могат да убият тумори при пациенти с рак в късен стадий
За разлика от обикновената Т-клетка, свръх Т-клетката има силата да се насочва към множество ракови протеини и следователно може да доведе до терапии, които...
Загубата на Y хромозома при мъжете насърчава растежа на рака, установява ново проучване
Учените откриват първите солидни доказателства, показващи връзка между загубата на Y хромозома и растежа на тумора при мъжете с напредване на възрастта. Учени от базирания...
От научната фантастика към реалността: Ксеноботите предефинират биотехнологиите
Някога представяли ли сте си свят, в който можем да използваме силата на жива клетка, за да изпълнява определени функции? Сега американските университети са...
Майка спечели от лотария с билет, който купува в чест на победата на дъщеря...
След като харчи всичките си спестявания, за да плати лечението на дъщеря си от рак на гърдата, една майка от Флорида получи подарък от...
Този малък робот може да плува в кръвта ни и да извършва клетъчен анализ
Учените създадоха хибриден микроробот, който е широк само 10 микрона - еквивалентен на размера на една човешка клетка. Изследователи от университета в Тел Авив в...
Ето идеалното 11-минутно правило за дълготраен здравословен живот
Отделете поне 11 минути на тялото си и то може да направи чудеса за вас. Изследователи от университета в Кеймбридж предлагат на хората да намалят...